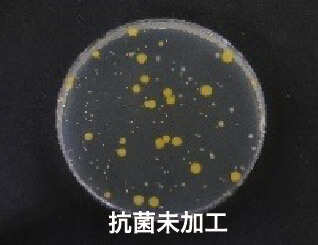

{{ 'fb_in_app_browser_popup.desc' | translate }} {{ 'fb_in_app_browser_popup.copy_link' | translate }}
{{ 'in_app_browser_popup.desc' | translate }}
{{word('consent_desc')}} {{word('read_more')}}
{{setting.description}}
{{ childProduct.title_translations | translateModel }}
{{ getChildVariationShorthand(childProduct.child_variation) }}
{{ getSelectedItemDetail(selectedChildProduct, item).childProductName }} x {{ selectedChildProduct.quantity || 1 }}
{{ getSelectedItemDetail(selectedChildProduct, item).childVariationName }}
分類
全店,全單滿3000元免運
指定分類,鏡片表面清潔服務 望遠鏡滿2萬元享保固內一年兩次,未滿則保固內一年一次
全店,台灣離島地區宅配貨到付款,全單訂購滿3000元免收「宅配貨到付款基本運費120元」。(僅需支付80元離島運送處理費)
全店,台灣離島地區宅配,全單訂購滿3000元免收「宅配基本運費100元」(僅需支付80元離島運送處理費)
商品存貨不足,未能加入購物車
您所填寫的商品數量超過庫存
{{'products.quick_cart.out_of_number_hint'| translate}}
{{'product.preorder_limit.hint'| translate}}
每筆訂單限購 {{ product.max_order_quantity }} 件
現庫存只剩下 {{ quantityOfStock }} 件

| 稜鏡形式 | 屋脊式稜鏡(roof prism) | 屋脊式稜鏡(roof prism) |
| 放大倍率 | 8倍 | 10倍 |
| 物鏡口徑 | 32mm | 32mm |
| 實際視野 | 8.3° | 6.7° |
| 眼視視野 | 66° | 67° |
| 良視距離 | 15.2mm | 15mm |
| 射出瞳徑 | 4mm | 3.2mm |
| 最短對焦距離 | 2m | 2m |
| 尺寸 (L×W×H) | 108.5×49.5×124mm | 108.5×49.5×124mm |
| 重量 | 375g | 370g |
| 防水等級 | 充氮氣密防水 | 充氮氣密防水 |


鴻宇光學清潔保養售後服務說明
保固期內
NT.20,000 以上望遠鏡:每年免費鏡片表面清潔保養兩次
未達 NT.20,000 望遠鏡:每年免費鏡片表面清潔保養一次
已過保固期
雙筒望遠鏡4個鏡片表面清潔 NT.1200
其他產品請洽0800-03-1234


